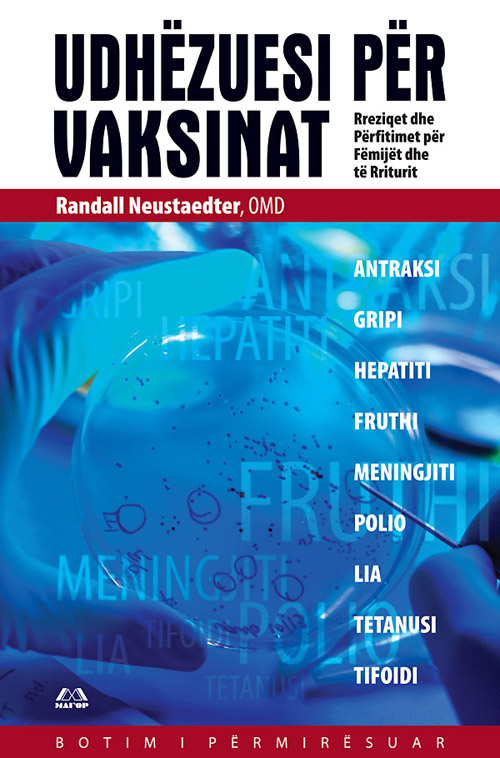
Udhëzuesi për vaksinat

Udhëzuesi për vaksinat
Издавач:
МАГОР
ISBN:
978-608-223-006-1
Година на издавање:
2010
Краток опис:
Udhëzuesi për vaksinat – Rreziqet dhe Përfitimet për fëmijët dhe të Rriturit është shkruar nga autori Randall Neustaedter, OMD. Libri ka dy botimi, për herë e parë është botuar në vitin 1996, dhe botimi i dytë është të vitit 2002. Përmbajtja e librit ndahet në 2 pjesa: Mundësitë dhe Vaksinat. Në këtë libër bëhet fjalë për problemeve të lidhura me vaksinimin e fëmijëve dhe e të rriturit, duke diskutuar për reagimeve të padëshirueshme, kimikateve në vaksinat, mjekimin e reagimeve të padëshirueshme dhe përjashtimeve ligjore për vaksinimin e të rriturit.
Поврзано
Оксфордски учебник по медицина Том 2

Автори:
Дејвид А. Ворел Тимоти М. Кокс Џон Д. Фирт Едвард Џ. Бенц јуниор
повеќе...Стратегија на пазарот за здравствена заштита - од планирање до акција

Автори:
Стивен Г. Хилстад Ерик Н. Берковиц
повеќе...Прирачник за нутриција и диететика
.jpg)
Автори:
Џоан Вебстер-Генди Анџела Маден Мишел Холдсворт
повеќе...Области
- Право, политички науки, дипломатија и локална самоуправа
- Култура и уметност
- Медицина, фармација, стоматологија и ветеринарна медицина
- Одбрана, безбедност, криминологија и разузнување
- Архитектура, градежништво, транспорт, механика, електроника и инженерство
- Социјална политика
- Ѕвезди на светската книжевност
- Земјоделство, шумарство и екологија
- 130 тома македонска книжевност
- Нобеловци
- Економија, менаџмент, маркетинг, банкарство, претприемаштво и финансии
- Хемија, физика, математика, биологија и географија
- Информатички науки, компјутерско инженерство и комуникациски системи
- Македонска литература на англиски јазик
- Македонски дејци
- Образование
- Историја, филозофија, антропологија и археологија
- Енергетика и природни ресурси






























.jpg)
.jpg)
.jpg)
.jpg)










.jpg)
.jpg)
.jpg)
.jpg)
.jpg)
.jpg)
.jpg)
.jpg)
.jpg)
.jpg)
.jpg)
.jpg)


.jpg)
.jpg)
.jpg)



.jpg)
.jpg)
.jpg)
.jpg)
.jpg)
.jpg)

